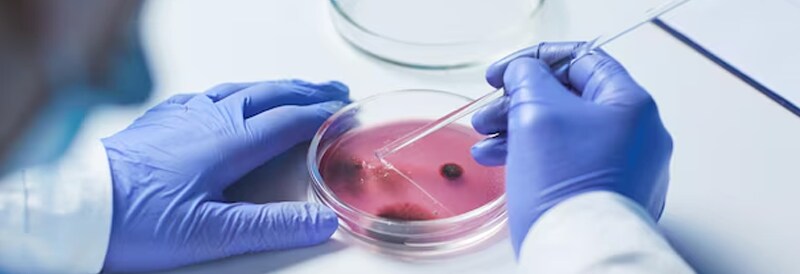

Médecine de laboratoire
Produits pour le laboratoire clinique
De la pathologie jusqu’à la sécurité, le canal commercial Fisher Scientific a les produits, spécialistes, et services pour être votre source de confiance pour les fournitures de médecine de laboratoire. Choisissez l’équipement, les tests de diagnostic, les solutions de disposition des déchets, les fournitures de collecte de spécimens, et plus, afin de soutenir vos patients tout au long de leur cheminement médical.
Explorez par catégorie
Ressources vedettes
Autres applications
Explorez les produits vedettes
Catalog Number 29-618-304
Catalog Number 22445095
Catalog Number 22-444-278
Catalog Number 95-664-0EC70
Catalog Number 7215448
Catalog Number 4121033
Catalog Number 7182275
Catalog Number 23043019